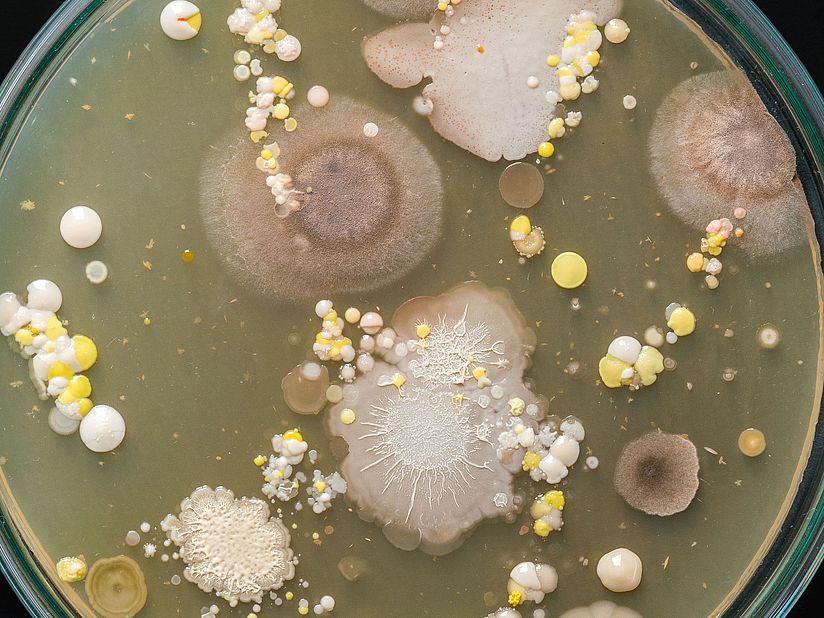
Petrieschale mit unerschiedlichen Arten von Bakterien, Viren und Pilzen.
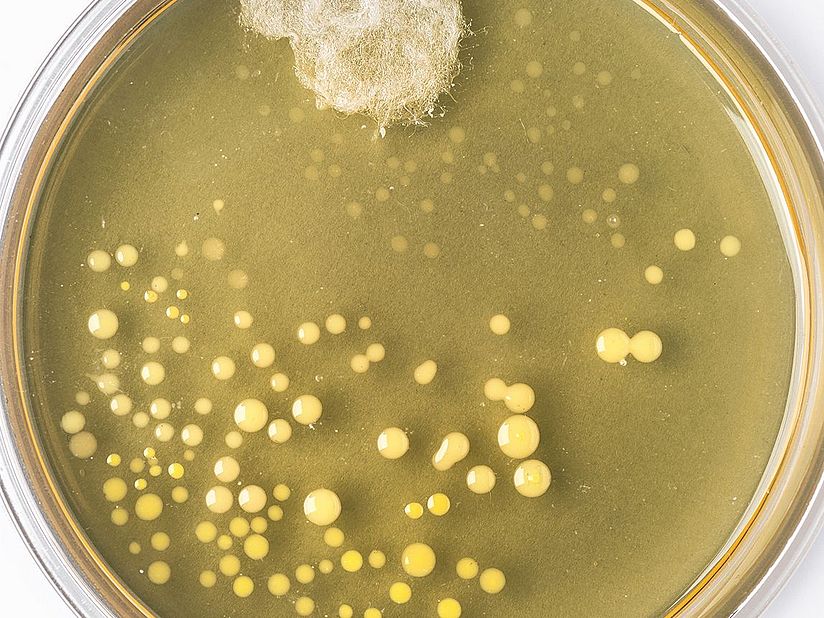
Nachbildung des berühmten Original-Petrischale von Alexander Fleming mit Schimmelpilz und Bakterienkolonien.

Autor/in Florian Breitsameter
Dr. Florian Breitsameter hat Chemie studiert und ist Kurator für Pharmazie und Medizintechnik am Deutschen Museum. Er entwickelte die Ausstellung »Gesundheit« und forscht u.a. zu Holzstandgefäßen in deutschen Apotheken und der Geschichte der Sulfonamide.
Sein Tipp für einen Besuch im Deutschen Museum: Die Historische Apotheke in der Ausstellung Gesundheit mit wunderschönen und wertvollen Apothekengefäßen, die u.a. Asseln, Rocheneier, getrocknete Kröten und Unicornum verum – echtes Einhorn – enthalten!